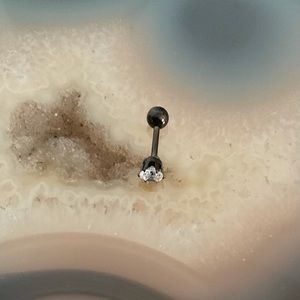

Gunmetal barbell earring cartilage tragus helix nose ring stud conch NEW
$10 $40
Discounted Shipping
Size
Like and save for later
Add To Bundle
Surgical steel gunmetal cubic zirconia stud earring
This listing is for one earring only
Can be used for multiple places
Shipping/Discount



ebbieshoney
and
2 others
like this
Trending Now
Find Similar Listings
Account is under Review
Comment posting is temporarily restricted. Our team will reach out to you shortly. To understand why, select
Learn More.